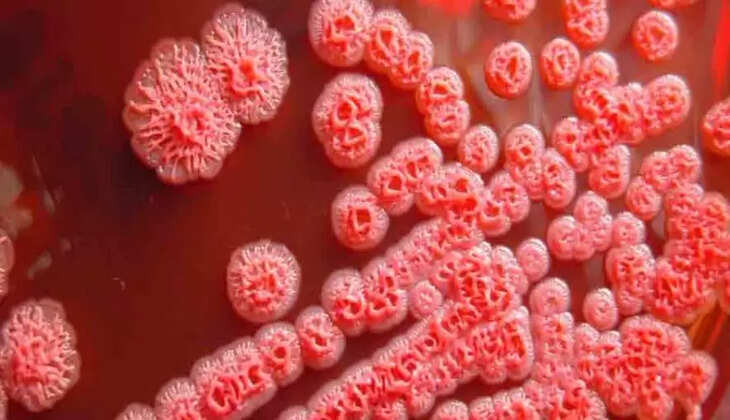
gv

മെലിയോയിഡോസിസ്; പയ്യന്നൂരിൽ മൂന്നുപേർക്കുകൂടി രോഗലക്ഷണങ്ങൾ
മെലിയോയിഡോസിസ് സ്ഥിരീകരിച്ച പയ്യന്നൂർ നഗരസഭയിലെ കോറോത്ത് മൂന്നുപേർക്കുകൂടി രോഗലക്ഷണങ്ങൾ കണ്ടെത്തി. ഇവരിൽനിന്നുള്ള സാമ്പിൾ പരിശോധനയ്ക്ക് അയച്ചിട്ടുണ്ട്. നഗരസഭാപരിധിയിലെ കോറോം വില്ലേജിലെ രണ്ടുപേർക്കാണ് അപൂർവരോഗമായ മെലിയോയിഡോസിസ് സ്ഥിരീകരിച്ചത്. ഇതിന് പുറമേയാണ് മൂന്നുപേരിൽ പനിയുൾപ്പെടെയുള്ള രോഗലക്ഷണങ്ങൾ കണ്ടെത്തിയത്. ഇവർ പഴയങ്ങാടി താലൂക്ക് ആസ്പത്രിയിൽ പരിശോധന നടത്തി.
രോഗലക്ഷണമുള്ളവരെ പരിശോധനയ്ക്ക് വിധേയരാക്കണമെന്ന് ആരോഗ്യവകുപ്പ് നിർദേശം നൽകിയിട്ടുണ്ട്. പരിശോധനയ്ക്കാവശ്യമായ കിറ്റുകൾ എത്തിച്ചാണ് ഇവരുടെ സാമ്പിളുകൾ ശേഖരിച്ചത്. ഇത് കണ്ണൂർ ഗവ. മെഡിക്കൽ കോളേജ് ആസ്പത്രി ലാബിലേക്കാണ് അയച്ചത്. ഒരാഴ്ചയോളമെടുക്കും പരിശോധനാഫലമറിയാൻ.
ബാക്ടീരിയ കാരണമുണ്ടാകുന്ന മെലിയോയിഡോസിസ് കോറോംഭാഗത്തെ 12 വയസ്സുകാരനിലാണ് ആദ്യം സ്ഥിരീകരിച്ചത്. പിന്നീട് 42-കാരനിലും രോഗം കണ്ടെത്തി. രോഗകാരിയായ ബാക്ടീരിയ രണ്ടുപേരിലും എത്തിയത് സമീപത്തുള്ള കുളത്തിൽനിന്നാകാമെന്നാണ് ആരോഗ്യവകുപ്പിന്റെ കണ്ടെത്തൽ.
ഇവർ രണ്ടുപേരും ഈ കുളത്തിൽ സ്ഥിരമായി കുളിക്കാറുണ്ടായിരുന്നു. ഈ കുളം ഉപയോഗിക്കുന്നതിന് വിലക്ക് ഏർപ്പെടുത്തിയിട്ടുണ്ട്. കുളത്തിലെ വെള്ളവും പരിശോധനക്കയച്ചു. ആരോഗ്യവകുപ്പ് പ്രദേശത്തെ ഇരുന്നൂറോളം വീടുകളിൽ വിവരശേഖരണം നടത്തി. പ്രദേശത്ത് മെഡിക്കൽ ക്യാമ്പ് നടത്തി ജനങ്ങളുടെ ആശങ്കയകറ്റണമെന്ന ആവശ്യം ഉയർന്നിട്ടുണ്ട്.
മെഡിക്കൽ ക്യാമ്പ് നടത്തേണ്ട സാഹചര്യമില്ലെന്നാണ് ആരോഗ്യവകുപ്പ് നിലപാട്. മൂന്നുപേർക്കുകൂടി രോഗലക്ഷണങ്ങൾ കണ്ടെത്തിയ സാഹചര്യത്തിൽ ശനിയാഴ്ച നഗരസഭയിൽ അടിയന്തര യോഗം ചേർന്നിരുന്നു.
കോറോം വില്ലേജിൽ മെലിയോയിഡോസിസ് രോഗം റിപ്പോർട്ട് ചെയ്തതുമായി ബന്ധപ്പെട്ട് ജനങ്ങൾ ആശങ്കാകുലരാകേണ്ടതില്ലെന്ന് ജില്ലാ മെഡിക്കൽ ഓഫീസർ അറിയിച്ചു.
രോഗാണുസാന്നിധ്യമുള്ള ജലത്തിലൂടെയും മണ്ണിലൂടെയുമാണ് രോഗം പകരുന്നത്. മനുഷ്യരിൽനിന്ന് മനുഷ്യരിലേക്ക് രോഗപ്പകർച്ചയില്ല. രോഗം റിപ്പോർട്ട് ചെയ്യപ്പെട്ട ഉടൻ പഴയങ്ങാടി താലൂക്ക് ആസ്പത്രിയിലെ പൊതുജനാരോഗ്യവിഭാഗത്തിന്റെ നേതൃത്വത്തിൽ വീടുകൾ സന്ദർശിച്ച് ബോധവത്കരണം, ക്ലോറിനേഷൻ എന്നിവ നടത്തി.
